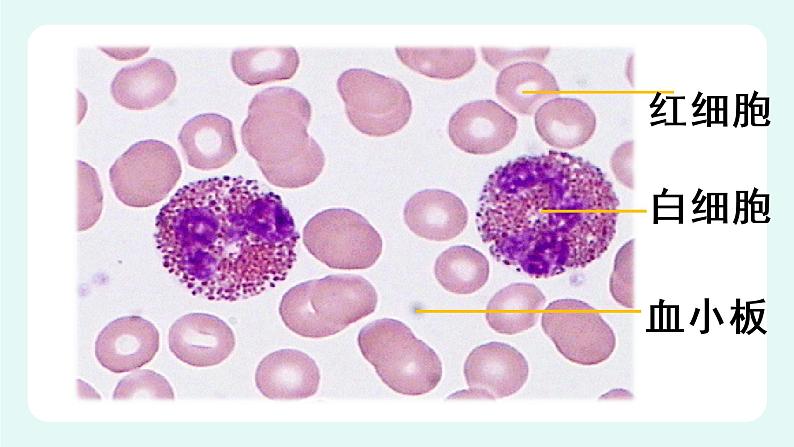
9.1血液(1)-课件第7页

北师大版七年级下册第1节 血液多媒体教学ppt课件
展开
这是一份北师大版七年级下册第1节 血液多媒体教学ppt课件,文件包含91血液1-课件ppt、91血液1-教案doc、91血液1-学案docx、91血液1-练习doc等4份课件配套教学资源,其中PPT共24页, 欢迎下载使用。
物质运输由哪个系统完成?
血液循环系统有什么组成?
1.含有抗凝剂的血液静置一段时间后,会出现什么现象?
2.血液分成了几层?综合以上资料,你认为血液可能是由哪几部分组成的?
分成了三层。血液是由上面淡黄色半透明的液体、下层深红色的部分以及中间很薄的一层白色物质组成。
二、血液的功能(一)血浆 1.成分:大量水(约占91%~92%)、 蛋白质(约占7%)、葡萄糖(约占0.1%)、无机盐(约占0.9%)和代谢废物等。2.功能:运载血细胞,运输营养物质和代谢废物。
1.在盛有新鲜血液的试管中加入少量柠檬酸钠,静止一段时间后,上层呈淡黄色半透明的的液体是( )A.红细胞 B.血清C.血小板 D.血浆2、下列含有血红蛋白的是( ) A.血浆 B.红细胞 C.白细胞判断对错:血浆的功能是运输氧和二氧化碳。( )
阅读课本28页找出下列问题的答案:1、红细胞的形状结构特点?2、正常人的红细胞的数量3、红细胞的寿命?4、红细胞由什么产生?5、红细胞有什么功能?
红细胞的形态对完成它的生理功能有什么意义?
红细胞的这种形态使它具有较大的表面积(约140 m2),所有红细胞表面积总计,相当于人体表面积的2000倍。从而能最大限度地适应其运输氧和二氧化碳的功能。
(1).数量男:5.0×1012个/L;女:4.2×1012个/L。(2).形态结构特点成熟红细胞没有细胞核,两面中间凹的圆饼状;细胞中有含铁的血红蛋白。男:120~160g/L;女:110~150g/L。(3).寿命与更新寿命约为120天,由红骨髓再生。
4.功能 红细胞中的血红蛋白运输氧气和二氧化碳。 动脉血:含氧气丰富的鲜红色的血 静脉血:含氧气少的暗红色的血
思考:图中哪一个是动脉血?哪一个是静脉血?
煤气(一氧化碳)中毒: 冬季煤炉取暖,或者液化气泄漏。
下列有关红细胞的叙述,错误的是( )。
A.红细胞体积较小,能运输一部分二氧化碳
B.红细胞中含血红蛋白,其主要功能是运输氧气
C.在血液中,红细胞的数量最多
D.成熟的红细胞呈两面凹的圆盘状,由细胞膜、细胞核和细胞质构成
能否尝试描述白细胞的形态特征?
英勇的战士——血液中白细胞
白细胞的数量如果忽然增多说明什么?
2、白细胞(1)数量 (4~10)×109个/ L。(2)形态结构特点 有细胞核,常分叶,有些能做变形运动。(3)寿命及再生 长短不一,由红骨髓产生。(4)功能 吞噬病菌等,对人体有防御和保护作用。
血癌病人(左)与正常人(右)血样对比
判断对错
1.血浆的功能是运输氧和二氧化碳。 ( )
2.成熟 的红细胞有细胞核。 ( )
3. 血液中的血细胞包括红细胞、血小板和白细胞。 ( )
相关课件
这是一份北师大版七年级下册第1节 血液课堂教学ppt课件,文件包含91血液1课件pptx、91血液1教学设计doc、91血液1练习doc、91血液1导学案docx、北师版生物七年级下册第9章第1节血液第1课时素材白细胞MPG、北师版生物七年级下册第9章第1节血液第1课时素材红细胞MPG、北师版生物七年级下册第9章第1节血液第1课时素材血小板MPG、北师版生物七年级下册第9章第1节血液第1课时素材观察血涂片wmv等8份课件配套教学资源,其中PPT共28页, 欢迎下载使用。
这是一份北师大版七年级下册第四单元 生物圈中的人第9章 人体内的物质运输第1节 血液课堂教学课件ppt,文件包含91血液课件ppt、91血液练习doc、91血液导学案doc、91血液教案doc等4份课件配套教学资源,其中PPT共13页, 欢迎下载使用。
这是一份北师大版七年级下册第1节 血液教学课件ppt,文件包含91血液2课件ppt、91血液2学案doc、91血液2练习doc、91血液2教学设计doc等4份课件配套教学资源,其中PPT共18页, 欢迎下载使用。










